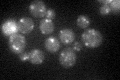
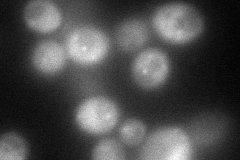
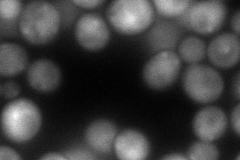
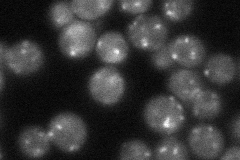
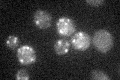

View description
Hydrophilic protein that acts in conjunction with SNARE proteins in targeting and fusion of ER to Golgi transport vesicles; component of the TRAPP (transport protein particle) complex
Localization:
Intensity:
Fold change:
Significance:
-
C’ GFP library in SD
punctate36.91 -
N' NOP1pr-GFP in SD
cytosol,punctate101.219 -
N' TEF2pr-mCherry in SD
cytosol,punctate104.96 -
N' NATIVEpr-GFP in SD
punctate45.829 -
N' TEF2pr-VC and Cyto-VN in SD

below threshold35.6992 -
C’ GFP library in SD+DTT

punctate30.20.81No -
C’ GFP library in SD+H2O2

punctate28.610.77No -
C’ GFP library in Starvation Media
punctate21.980.59Yes -
C’ GFP library on the background of Pup2-DaMP

punctate -
C’ GFP library on the background of CCT mutant

punctate40.77961.10455No
